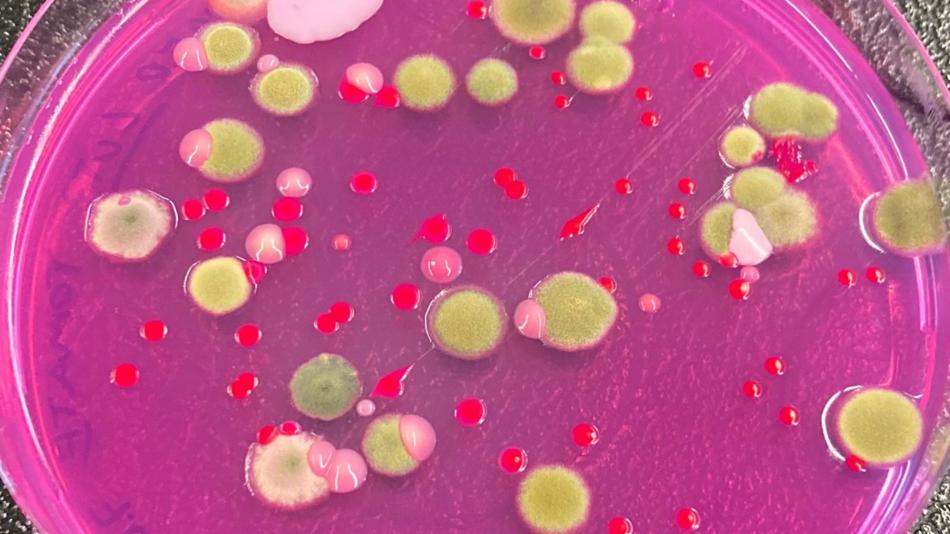
Petrischale mit pinkfarbenem Nährmedium, auf dem verschiedenfarbige Bakterien- und Pilzkolonien wachsen

Ausstellung
Können wir mit Hilfe von Mikroorganismen erneuerbare Kunststoffe herstellen?
Thema:
Naturwissenschaften
Schlagworte:
Biologie, Chemie und Nachhaltigkeit
Altersgruppe:
10 bis 14 Jahre, 14 bis 18 Jahre und ab 18 Jahre
Zielgruppe:
Barrierefrei und für Gruppen & Schulklassen
Durchschnittliche Verweildauer: 10 Minuten
© Martin Altvater
Besucherinformation
Anfahrtsbeschreibung: Sie erreichen den Standort am besten mit den öffentlichen Verkehrsmitteln. Der Bahnhof Heiligenstadt (U4, S45, S40, 5B, 10A) liegt in 5 Minuten Fußweite. Die Buslinie 10A verbindet den Standort Türkenschanze und den Standort Muthgasse! Sonst erreichen Sie uns auch mit den Buslinien 5B und 11A mit Ausstieg an der Haltestelle Michael-Neumann-Gasse.
Dieser Ausstellungsstandort ist barrierefrei zugänglich und verfügt über barrierefreie Toiletten.
BOKU University
Department für Biotechnologie und Lebensmittelwissenschaften
Institut für Mikrobiologie und Mikrobielle Biotechnologie
BOKU-Standort Muthgasse
Muthgasse 18, 1190 Wien
Öffnungszeiten
Erster Einlass: 17:00
Letzter Einlass: 22:55
21 weitere Stationen an diesem Standort
-
Experiment / VorführungWie finden Immunzellen Gefahren im Zuckerwald?Thema: Gesundheit NaturwissenschaftenImmunzellen müssen Gefahr im molekularen Maßstab erkennen. T-Zellen erkennen Antigene, indem sie engen Kontakt herstellen und winzige Kräfte ausüben. Doch jede Zelle ist von einem dichten „Zuckerwald“ (der Glykokalyx) umgeben, der den Zugang blockieren kann. Diese Station zeigt, wie Kräfte und Barrieren die Immunüberwachung beeinflussen.BOKU University17:00 - 21:00
-
 Experiment / VorführungVom Feind zum Helfer: Können Tabakpflanzen als Produktionsplattform für Biopharmazeutika dienen?Thema: Gesundheit UmweltAn dieser Station entdecken Besucher:innen Tabak als „grüne Produktionsfabrik“, in der wertvolle Medikamente wie Antikörper und Impfstoffe hergestellt werden können. Wie kommt die Medizin in die Pflanze? Das erleben Sie hier selbst: Sie bringen Gene in Pflanzen ein, verfolgen den Prozess Schritt für Schritt und können das Ergebnis unter dem Mikroskop nachverfolgen.BOKU University17:00 - 22:55
Experiment / VorführungVom Feind zum Helfer: Können Tabakpflanzen als Produktionsplattform für Biopharmazeutika dienen?Thema: Gesundheit UmweltAn dieser Station entdecken Besucher:innen Tabak als „grüne Produktionsfabrik“, in der wertvolle Medikamente wie Antikörper und Impfstoffe hergestellt werden können. Wie kommt die Medizin in die Pflanze? Das erleben Sie hier selbst: Sie bringen Gene in Pflanzen ein, verfolgen den Prozess Schritt für Schritt und können das Ergebnis unter dem Mikroskop nachverfolgen.BOKU University17:00 - 22:55 -
 MitmachstationWhy don't plant cells burst like overfilled balloons?Thema: UmweltA transparent, expandable “plant cell” model demonstrates how vacuoles generate internal pressure and how flexible cell walls adapt to it. By inflating a balloon inside a movable box, visitors can see how plant cells grow under tension and how stress is managed through cellular quality-control mechanisms. The demo is hands-on, visual, and suitable for all ages.BOKU University17:00 - 22:55
MitmachstationWhy don't plant cells burst like overfilled balloons?Thema: UmweltA transparent, expandable “plant cell” model demonstrates how vacuoles generate internal pressure and how flexible cell walls adapt to it. By inflating a balloon inside a movable box, visitors can see how plant cells grow under tension and how stress is managed through cellular quality-control mechanisms. The demo is hands-on, visual, and suitable for all ages.BOKU University17:00 - 22:55 -
 Experiment / VorführungWas ist "Circular Bioengineering"?Thema: GesundheitAn dieser Station werden Enzyme als Biokatalysatoren für die Umwandlung erneuerbarer Substrate. Besucherinnen und Besucher können praktische Aufgaben wie Pipettieren, die Verwendung von Elektroden und einfache Messungen unter Anleitung der erfahrenden Forscherinnen und Forscher ausprobieren.BOKU University17:00 - 22:55
Experiment / VorführungWas ist "Circular Bioengineering"?Thema: GesundheitAn dieser Station werden Enzyme als Biokatalysatoren für die Umwandlung erneuerbarer Substrate. Besucherinnen und Besucher können praktische Aufgaben wie Pipettieren, die Verwendung von Elektroden und einfache Messungen unter Anleitung der erfahrenden Forscherinnen und Forscher ausprobieren.BOKU University17:00 - 22:55 -
 AusstellungCan Analytical Chemistry Be Transformed into an Artistic Medium to Communicate Research Networks and Human Identity?Thema: NaturwissenschaftenAn art–science installation using thin layer chromatography (TLC) to visualize scientific complexity and collective research. Individual TLC plates represent PhD projects and merge into a chaotic whole, paired with layered researcher portraits. An interactive station invites visitors to create their own TLC plates using safe, everyday materials.BOKU University17:00 - 22:55
AusstellungCan Analytical Chemistry Be Transformed into an Artistic Medium to Communicate Research Networks and Human Identity?Thema: NaturwissenschaftenAn art–science installation using thin layer chromatography (TLC) to visualize scientific complexity and collective research. Individual TLC plates represent PhD projects and merge into a chaotic whole, paired with layered researcher portraits. An interactive station invites visitors to create their own TLC plates using safe, everyday materials.BOKU University17:00 - 22:55 -
 MitmachstationDie Welt der Antikörper-Engineere schon entdeckt?Thema: GesundheitAntikörper sind eines der coolsten Werkzeuge in der Humanmedizin. Erfahren Sie spannende Informationen über durchdachte Antikörper-Designs und wie wir diese Proteine zu unserem Vorteil nutzen können! Wir zeigen Ihnen mit interaktiven Spielen, was Antikörper so einzigartig macht. Lassen Sie uns zusammen Spaß haben und lernen!BOKU University17:00 - 22:55
MitmachstationDie Welt der Antikörper-Engineere schon entdeckt?Thema: GesundheitAntikörper sind eines der coolsten Werkzeuge in der Humanmedizin. Erfahren Sie spannende Informationen über durchdachte Antikörper-Designs und wie wir diese Proteine zu unserem Vorteil nutzen können! Wir zeigen Ihnen mit interaktiven Spielen, was Antikörper so einzigartig macht. Lassen Sie uns zusammen Spaß haben und lernen!BOKU University17:00 - 22:55 -
 AusstellungPuzzlezellen aus Nussschalen für neue nachhaltige Materialien?Thema: GesundheitWalnuss und Pistazienschalen sind aus gelappten Zellen aufgebaut, die wie in einem 3D-Puzzle genau zusammenpassen und ineinandergreifen. Dadurch werden die mechanischen Eigenschaften verbessert und die Oberfläche der Zellen vergrößert. Bisher werden Nussschalen hauptsächlich verbrannt, aber kann man diese Zellen auflösen und als neue nachhaltige Verbundwerkstoffe wieder zusammenbauen?BOKU University17:00 - 22:55
AusstellungPuzzlezellen aus Nussschalen für neue nachhaltige Materialien?Thema: GesundheitWalnuss und Pistazienschalen sind aus gelappten Zellen aufgebaut, die wie in einem 3D-Puzzle genau zusammenpassen und ineinandergreifen. Dadurch werden die mechanischen Eigenschaften verbessert und die Oberfläche der Zellen vergrößert. Bisher werden Nussschalen hauptsächlich verbrannt, aber kann man diese Zellen auflösen und als neue nachhaltige Verbundwerkstoffe wieder zusammenbauen?BOKU University17:00 - 22:55 -
MitmachstationWie helfen Zellfabriken bei der Produktion von Arzneimitteln und Wertstoffen?Thema: GesundheitZellfabriken wie Bakterien, Pilze oder tierische Zellen können mittels Gentechnik dazu gebracht werden für den Menschen wichtige Wirkstoffe zu produzieren. Die Vermehrung dieser Zellen und Produktion der Wirkstoffe findet in Rührkesseln (Fermentoren) statt. Danach muss das Produkt mittels unterschiedlicher Verfahren von den Zellen getrennt und gereinigt werden.BOKU University17:00 - 22:55
-
 MitmachstationMassen erfassen - Wie hilft Massenspektrometrie dabei, Stoffe zu untersuchen?Thema: NaturwissenschaftenKinder & Erwachsene erfahren, wie Massenspektrometrie genutzt wird, um verschiedene Moleküle unserer Umwelt zu untersuchen und zu identifizieren. Sie können Moleküle selbst bauen und danach mit Hilfe einer Waage untersuchen. Mit einer speziellen Laborwaage können Sie ausprobieren, wie Forscher*innen sich Hochauflösung für schwierige Fragen zu Nutze machen. Weiters werden konkrete Beispiele aus der Forschung gezeigt.BOKU University17:00 - 22:55
MitmachstationMassen erfassen - Wie hilft Massenspektrometrie dabei, Stoffe zu untersuchen?Thema: NaturwissenschaftenKinder & Erwachsene erfahren, wie Massenspektrometrie genutzt wird, um verschiedene Moleküle unserer Umwelt zu untersuchen und zu identifizieren. Sie können Moleküle selbst bauen und danach mit Hilfe einer Waage untersuchen. Mit einer speziellen Laborwaage können Sie ausprobieren, wie Forscher*innen sich Hochauflösung für schwierige Fragen zu Nutze machen. Weiters werden konkrete Beispiele aus der Forschung gezeigt.BOKU University17:00 - 22:55 -
MitmachstationWelche Geheimnisse haben unsere Lebensmittel?Thema: UmweltWir öffnen unser Lebensmitteltechnikum und Sensoriklabor mit Stationen rund um die Herstellung und Qualität von Lebensmitteln. Versuche, Kostproben, wissenschaftliche Poster und eine Mitmachstation für Kids erwarten junge und junggebliebene Freizeitforscher:innen. Betrieben wird die Station von den AGs für Lebensmitteltechnologie, Lebensmittel- und Biotechnologie, Lebensmittelmikrobiologie und Lebensmittelsensorik.BOKU University17:00 - 20:30
-
MitmachstationWelche Vor- und Nachteile hat der Einsatz von künstlicher Intelligenz (KI) in der biotechnologischen Forschung?Thema: Digitalisierung NaturwissenschaftenEntwicklungen im Bereich von Sprachmodellen (GPT) und KI-Agenten haben das Potential die Produktivität von Forscher:innen in der Biotechnologie zu verbessern. Die Station wird Vorteile und Gefahren des Einsatzes von KI in Forschung und Entwicklung diskutieren. Jüngeres Publikum hat die Gelegenheit einen grundlegenden Mechanismus der Entscheidungsfindung in KI Systemen in einer Mitmachstation spielerisch zu verstehen.BOKU University17:00 - 22:55
-
Experiment / VorführungWas haben Popcorn und Wärmepumpen gemeinsam?Thema: EnergieBesucher:innen erleben live, wie Energie genutzt, umgewandelt und effizient eingesetzt wird - zum Einen durch den Einsatz von einer beheizten Wirbelschicht, mit der Popcorn zum "Tanzen" gebracht wird und zum Anderen indem sie zeigen, wie Wärmepumpen Energie aus der Umgebung aufnehmen, auf ein höheres Temperaturniveau anheben und so effizientes, klimafreundliches Heizen ermöglichen.BOKU University17:00 - 22:55
-
Experiment / VorführungFitnessstudio für Immunzellen - Wie können T-Zellen trainiert werden, damit Sie Krebs erkennen?NeuThema: GesundheitProteine sind die kleinen Helfer in unserem Körper. Wir verändern sie so, dass sie neue Aufgaben übernehmen und in der Medizin eingesetzt werden können. Sehen Sie, wie sie CAR-T-Zellen helfen, Krebszellen gezielt aufzuspüren!BOKU University17:00 - 22:55
-
WorkshopDie heimlichen Alleskönner: Wie Hämenzyme Medizin, Umwelt und Industrie revolutionierenNeuThema: GesundheitDie Forschung an Enzymen, insbesondere Hämenzymen, ist zentral für die Proteinbiochemie. Ihr besseres Verständnis ermöglicht Fortschritte in der Entwicklung neuer Antibiotika, beim Abbau von Umweltgiften und bei energieeffizienten Alternativen zur chemischen Produktion.BOKU University17:00 - 22:55
-
 AusstellungHaben Zellen „Organe“?Thema: NaturwissenschaftenZellen, egal, ob in Mikroorganismen, Pflanzen oder Tieren, sind aus sogenannten Organellen zusammengesetzt. Jedes Organell, welches man sich wie Organe im menschlichen Körper vorstellen kann, dient einer Funktion und ist Teil einer Reihe an Prozessen in der Zelle. Doch welche Organellen kommen in Zellen vor und welche Funktionen haben diese? Das wird unter anderem anhand des endoplasmatischen Retikulum beantwortet.BOKU University17:30 - 22:55
AusstellungHaben Zellen „Organe“?Thema: NaturwissenschaftenZellen, egal, ob in Mikroorganismen, Pflanzen oder Tieren, sind aus sogenannten Organellen zusammengesetzt. Jedes Organell, welches man sich wie Organe im menschlichen Körper vorstellen kann, dient einer Funktion und ist Teil einer Reihe an Prozessen in der Zelle. Doch welche Organellen kommen in Zellen vor und welche Funktionen haben diese? Das wird unter anderem anhand des endoplasmatischen Retikulum beantwortet.BOKU University17:30 - 22:55 -
 AusstellungIndustrielle Biotechnologie: Wie können Mikroorganismen im Klimawandel helfen?Thema: GesundheitMikroorganismen helfen schon heute, Medikamente und Alltagsprodukte herzustellen – meist aus Zucker. Doch Zuckeranbau verbraucht Fläche und Wasser und konkurriert mit unserer Ernährung. Gleichzeitig entsteht zu viel CO₂: ein Klimaproblem, aber auch ein wertvoller Rohstoff. Forschende bringen Mikroben bei, CO₂ und Abfälle in nützliche Chemikalien umzuwandeln – für eine nachhaltige Produktion.BOKU University17:00 - 22:55
AusstellungIndustrielle Biotechnologie: Wie können Mikroorganismen im Klimawandel helfen?Thema: GesundheitMikroorganismen helfen schon heute, Medikamente und Alltagsprodukte herzustellen – meist aus Zucker. Doch Zuckeranbau verbraucht Fläche und Wasser und konkurriert mit unserer Ernährung. Gleichzeitig entsteht zu viel CO₂: ein Klimaproblem, aber auch ein wertvoller Rohstoff. Forschende bringen Mikroben bei, CO₂ und Abfälle in nützliche Chemikalien umzuwandeln – für eine nachhaltige Produktion.BOKU University17:00 - 22:55 -
 AusstellungWie sieht ein Wohnzimmer für Stammzellen aus?Thema: Gesundheit NaturwissenschaftenDieser Stand umfasst eine Diashow, Demomaterial wie gefärbte Stammzellen unter dem Mikroskop, einen Inkubator, einen Matriderm und Stammzellen-Plüschtiere.BOKU University17:00 - 22:55
AusstellungWie sieht ein Wohnzimmer für Stammzellen aus?Thema: Gesundheit NaturwissenschaftenDieser Stand umfasst eine Diashow, Demomaterial wie gefärbte Stammzellen unter dem Mikroskop, einen Inkubator, einen Matriderm und Stammzellen-Plüschtiere.BOKU University17:00 - 22:55 -
 MitmachstationMein Test ist positiv - Bin ich jetzt krank?Thema: GesundheitZusammen mit den BOKU-Wissenschafter:innen sehen Sie sich die Eigenschaften medizinischer Tests an und verwenden Bayes Gesetz zur Bestimmung des Krankheitsrisikos nach einem positiven Test. Dabei wird klar, wie die Prävalenz einer Krankheit und das persönliche ursprüngliche Risiko das Ergebnis stark beeinflussen.BOKU University18:00 - 19:55
MitmachstationMein Test ist positiv - Bin ich jetzt krank?Thema: GesundheitZusammen mit den BOKU-Wissenschafter:innen sehen Sie sich die Eigenschaften medizinischer Tests an und verwenden Bayes Gesetz zur Bestimmung des Krankheitsrisikos nach einem positiven Test. Dabei wird klar, wie die Prävalenz einer Krankheit und das persönliche ursprüngliche Risiko das Ergebnis stark beeinflussen.BOKU University18:00 - 19:55 -
 MitmachstationWo beginnt er, der Weg in die Forschung?Thema: NaturwissenschaftenAn dieser Station der BOKU können Besuchende im Übungslabor der Mikrobiologie selbst zu Forschenden werden: Vom Mikroskopieren kleinster Organismen über das Identifizieren von Bakterien bis hin zum Aufspüren neuer Antibiotikaproduzenten können Sie hier in die (fast) unsichtbare Welt der Mikroorganismen eintauchen.BOKU University17:00 - 22:55
MitmachstationWo beginnt er, der Weg in die Forschung?Thema: NaturwissenschaftenAn dieser Station der BOKU können Besuchende im Übungslabor der Mikrobiologie selbst zu Forschenden werden: Vom Mikroskopieren kleinster Organismen über das Identifizieren von Bakterien bis hin zum Aufspüren neuer Antibiotikaproduzenten können Sie hier in die (fast) unsichtbare Welt der Mikroorganismen eintauchen.BOKU University17:00 - 22:55 -
 Experiment / VorführungWas flitzt da durch die Zelle?Thema: Naturwissenschaften UmweltTauchen Sie ein in den Mikrokosmos! Wir zeigen Ihnen mit hochauflösenden Mikroskopen, dass Pflanzen im Inneren alles andere als starr sind. Beobachten Sie wandernde Chloroplasten und lernen Sie, wie wir Zellorganellen mit Fluoreszenz zum Leuchten bringen. Bei uns werden Sie zur Forscherin oder zum Forscher!BOKU University17:00 - 19:15
Experiment / VorführungWas flitzt da durch die Zelle?Thema: Naturwissenschaften UmweltTauchen Sie ein in den Mikrokosmos! Wir zeigen Ihnen mit hochauflösenden Mikroskopen, dass Pflanzen im Inneren alles andere als starr sind. Beobachten Sie wandernde Chloroplasten und lernen Sie, wie wir Zellorganellen mit Fluoreszenz zum Leuchten bringen. Bei uns werden Sie zur Forscherin oder zum Forscher!BOKU University17:00 - 19:15 -
 MitmachstationFrom Farm to Fork – Wie kommt unser Essen auf den Tisch?Thema: Gesundheit UmweltEntdecken Sie, wie Wissenschaft Lebensmittel tierischen Ursprungs entlang der gesamten Wertschöpfungskette prägt – vom Bauernhof bis auf den Teller. Erfahren Sie, wie Futterqualität eine nachhaltige Tierhaltung unterstützt, wie Ernährung die Darmgesundheit von Nutztieren beeinflusst und wie Fleisch und Eier wissenschaftlich auf ihre Qualität geprüft werden.BOKU University17:00 - 21:45
MitmachstationFrom Farm to Fork – Wie kommt unser Essen auf den Tisch?Thema: Gesundheit UmweltEntdecken Sie, wie Wissenschaft Lebensmittel tierischen Ursprungs entlang der gesamten Wertschöpfungskette prägt – vom Bauernhof bis auf den Teller. Erfahren Sie, wie Futterqualität eine nachhaltige Tierhaltung unterstützt, wie Ernährung die Darmgesundheit von Nutztieren beeinflusst und wie Fleisch und Eier wissenschaftlich auf ihre Qualität geprüft werden.BOKU University17:00 - 21:45










